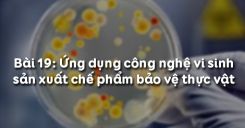
Bài 20: Ứng dụng công nghệ vi sinh sản xuất chế phẩm bảo vệ thực vật

Chương 1 Trồng Trọt Lâm Nghiệp Đại Cương là một nội dung quan trọng luôn có trong nội dung ôn tập, trong các đề thi học kì và đề kiểm tra của chương trình Công Nghệ lớp 10. Với mong muốn giúp các em học sinh có thêm nhiều tài liệu tham khảo tốt , Học247 đã tổng hợp và biên soạn lại nội dung đầy đủ của chương 1 qua các phần tóm tắt lý thuyết trọng tâm, các đề thi trắc nghiệm online hoàn toàn miễn phí, các ví dụ tương ứng có hướng dẫn giải chi tiết và phương pháp giải các bài tập SGK. Thông qua các bài giảng lý thuyết về những kiến thức cơ bản nhất của giống cây trồng, vị trí, vai trò và tầm quan trọng của Lâm nghiệp trong nền kinh tế, mục đích và phương pháp công tác sản xuất giống cây trồng... sẽ giúp các em ôn tập và rèn luyện thêm nhiều kĩ năng giải bài tập môn Công Nghệ 10. Mời các em cùng theo dõi.
-
Công nghệ 10 Bài 1: Bài mở đầu
Nội dung bài học Bài 1: Bài mở đầu dưới đây nhằm giúp các em biết được vị trí, vai trò và tầm quan trọng của các ngành nông, lâm, nghư nghiệp trong nền kinh tế quốc dân; những thuận lợi và khó khăn của điều kiện tự nhiên, xã hội của nước ta ảnh hưởng đến sự phát triển nông, lâm, ngư nghiệp và biết tiếp cận tình hình thực tiễn sản xuất nông, lâm, ngư nghiệp của nước ta trong thời gian hiện tại và tương lai. Để biết rõ hơn về nội dung chi tiết, mời các em cùng theo dõi bài học.
- Trắc nghiệm Công nghệ 10 Bài 1: Bài mở đầu
- Giải bài tập SGK Bài 1 Công nghệ 10
- Hỏi đáp về Bài mở đầu - Công nghệ 10
5 trắc nghiệm 3 bài tập 30 hỏi đáp
-
Công nghệ 10 Bài 2: Khảo nghiệm giống cây trồng
Nội dung bài học bài Khảo nghiệm giống cây trồng dưới đây nhằm giúp các em hiểu được mục đích, ý nghĩa của công tác khảo nghiệm giống cây trồng; nắm được nội dung của các thí nghiệm so sánh giống, kiểm tra kĩ thuật, sản xuất quảng cáo trong hệ thống khảo nghiệm giống cây trồng;... Để biết rõ hơn về nội dung chi tiết, mời các em cùng theo dõi.
- Trắc nghiệm Công nghệ 10 Bài 2: Khảo nghiệm giống cây trồng
- Giải bài tập SGK Bài 2 Công nghệ 10
- Hỏi đáp về Khảo nghiệm giống cây trồng - Công nghệ 10
10 trắc nghiệm 4 bài tập 27 hỏi đáp
-
Công nghệ 10 Bài 3: Sản xuất giống cây trồng
Mục đích của bài Sản xuất giống cây trồng nhằm giúp các em biết được những mục đích của công tác sản xuất giống cây trồng, hệ thống sản xuất giống cây trồng và biết được quy trình sản xuất giống cây trồng tự thụ phấn theo sơ đồ duy trì và sơ đồ phục tráng. Để biết rõ hơn về nội dung chi tiết, mời các em cùng theo dõi nội dung bài học dưới đây.
- Trắc nghiệm Công nghệ 10 Bài 3: Sản xuất giống cây trồng
- Giải bài tập SGK Bài 3 Công nghệ 10
- Hỏi đáp về Sản xuất giống cây trồng - Công nghệ 10
10 trắc nghiệm 4 bài tập 30 hỏi đáp
-
Công nghệ 10 Bài 4: Sản xuất giống cây trồng (tiếp theo)
Trong bài trước chúng ta đã tìm hiểu xong mục đích của công tác sản xuất giống cây trồng, hệ thống sản xuất giống cây trồng, quy trình sản xuất giống cây trồng tự thụ phấn. Bài học dưới đây mời các em cùng tìm hiểu các nội dung còn lại: Quy trình sản xuất giống cây trồng thụ phấn chéo, quy trình sản xuất giống ở cây trồng nhân giống vô tính và giống cây rừng được sản xuất theo quy trình như thế nào?
-
Công nghệ 10 Bài 5: Thực hành Xác định sức sống của hạt
Trong nội dung của Bài 5: Thực hành Xác định sức sống của hạt dưới đây chúng ta sẽ cùng nhau tìm hiểu cách chọn được hạt dủ tiêu chuẩn để xác định sức sống của hạt trước khi gieo trồng, thực hiện đúng quy trình kỹ thuật trong quy trình xác định sức sống của hạt và tính tỷ lệ hạt sống. Mời các em cùng theo bài thực hành.
-
Công nghệ 10 Bài 6: Ứng dụng công nghệ nuôi cấy mô tế bào trong nhân giống cây trồng nông, lâm nghiệp
Nội dung của Bài 6: Ứng dụng công nghệ nuôi cấy mô tế bào trong nhân giống cây trồng nông, lâm nghiệp dưới đây chúng ta sẽ cùng nhau tìm hiểu thế nào là nuôi cấy mô tế bào, cơ sở khoa học của phương pháp này? Quy trình công nghệ nhân giống bằng nuôi cấy mô tế bào? Mời các em cùng theo dõi bài học để tìm hiểu nội dung chi tiết.
-
Công nghệ 10 Bài 7: Một số tính chất của đất trồng
-
Công nghệ 10 Bài 8: Thực hành xác định độ chua của đất
-
Công nghệ 10 Bài 9: Biện pháp cải tạo và sử dụng đất xám bạc màu, đất xói mòn mạnh trơ sỏi đá
Đất Việt Nam được hình thành trong điều kiện nhiệt đới nóng ẩm nên chất hữu cơ và mùn trong đất rất dễ bị khoang hóa, các chất dinh dưỡng trong đất dễ hòa tan và bị nước mưa rửa trôi. Khoảng 70% diện tích đất tự nhiên phân bố ở vùng đồi núi nên đất chịu ảnh hưởng mạnh của quá trình xói mòn. Đất bị thoái hóa mạnh. Diện tích đất xấu nhiều hơn đất tốt. Trong số các loại đất xấu cần cải tạo, phải kể đến đất xám bạc màu, đất xói mòn mạnh trơ sỏi đá, đất mặn, đất phèn. Vậy phải làm thế nào để cải tạo và sử dụng các loại đất này cho hợp lí? Mời các em cùng theo dõi bài học Bài 9: Biện pháp cải tạo và sử dụng đất xám bạc màu, đất xói mòn mạnh trơ sỏi đá dưới đây để cùng tìm hiểu nội dung chi tiết.
-
Công nghệ 10 Bài 10: Biện pháp cải tạo và sử dụng đất mặn, đất phèn
Trong Bài 9: Biện pháp cải tạo và sử dụng đất xám bạc màu, đất xói mòn mạnh trơ sỏi đá chúng ta đã cùng nhau tìm hiểu về biện pháp cải tạo và sử dụng đất xám bạc màu, đất xói mòn mạnh trơ sỏi đá. Bài học Bài 10: Biện pháp cải tạo và sử dụng đất mặn, đất phèn dưới đây, mời các em cùng theo dõi nội dung còn lại đó là biện pháp cải tạo và sử dụng đất mặn, đất phèn.
-
Công nghệ 10 Bài 11: Thực hành quan sát phẫu diện đất
-
Công nghệ 10 Bài 12: Đặc điểm, tính chất, kỹ thuật sử dụng một số loại phân bón thông thường
-
Công nghệ 10 Bài 13: Ứng dụng công nghệ vi sinh trong sản xuất phân bón
-
Công nghệ 10 Bài 14: Thực hành trồng cây trong dung dịch
Mục tiêu của Bài 14: Thực hành trồng cây trong dung dịch nhằm giúp các em biết phương pháp và trồng được cây trong dung dịch; rèn luyện cho các em kĩ năng thực hành, tính cẩn thận, tỉ mỉ; thực hiện đúng quy trình, bảo đảm an toàn lao động và vệ sinh môi trường. Mời các em cùng theo dõi bài học dưới đây.
-
Công nghệ 10 Bài 15: Điều kiện phát sinh, phát triển của sâu, bệnh hại cây trồng
Sự phát sinh, phát triển của sâu, bệnh hại cây trồng phụ thuộc vào các yếu tố: nguồn sâu, bệnh hại; điều kiện khí hậu, đất đai; giống cây trồng và chế độ chăm sóc. Để biết rõ hơn về các yếu tố này, mời các em theo dõi Bài 15: Điều kiện phát sinh, phát triển của sâu, bệnh hại cây trồng dưới đây cùng tìm hiểu chi tiết.
-
Công nghệ 10 Bài 16: Thực hành nhận biết một số loại sâu, bệnh hại lúa
Mục tiêu của Bài 16: Thực hành nhận biết một số loại sâu, bệnh hại lúa nhằm giúp các em nhận dạng được một số sâu như sâu đục thân bướm hai chấm, sâu cuốn lá lúa loại nhỏ, rầy nâu hại lúa; và biết được các loại bệnh hại cây trồng như bệnh bạc lá lúa, bệnh khô vằn, bệnh đạo ôn;.... Mời các em cùng theo dõi bài thực hành dưới đây để tìm hiểu nội dung chi tiết.
-
Công nghệ 10 Bài 17: Phòng trừ tổng hợp dịch hại cây trồng
Nội dung Bài 17: Phòng trừ tổng hợp dịch hại cây trồng dưới đây các em sẽ cùng tìm hiểu thế nào là phòng trừ tổng hợp dịch hại cây trồng?, nguyên lí cơ bản và các biện pháp chủ yếu sử dụng trong phòng trừ tổng hợp dịch hại cây trồng,... Mời các em cùng theo dõi bài học để tìm hiểu nội dung chi tiết.
-
Công nghệ 10 Bài 18: Thực hành pha chế dung dịch Boóc đô phòng, trừ nấm hại
Dung dịch Boóc-đô được sử dụng rộng rãi trong việc bảo vệ thực vật để phòng trừ các bệnh có nguồn gốc từ nấm và vi khuẩn. Vậy phải pha chế để sử dụng như thế nào là đúng cách? Mời các bạn cùng theo dõi nội dung Bài 18: Thực hành pha chế dung dịch Boóc đô phòng, trừ nấm hại để hiểu rõ hơn về qui trình pha chế.
-
Công nghệ 10 Bài 19: Ảnh hưởng của thuốc hóa học bảo vệ thực vật đến quần thể sinh vật và môi trường
Thuốc hóa học bảo vệ thực vật có mặt tích cực là tiêu diệt được sâu, bệnh, làm giảm thiệt hại do chúng gây ra. Tuy nhiên việc sử dụng chúng cũng có những mặt hạn chế nhất định. Vậy những hạn chế đó có ảnh hưởng như thế nào đến quần thể sinh vật và môi trường thì mời các em cùng theo dõi nội dung Bài 19: Ảnh hưởng của thuốc hóa học bảo vệ thực vật đến quần thể sinh vật và môi trường dưới đây để tìm hiểu chi tiết về vấn đề này.
-
Công nghệ 10 Bài 20: Ứng dụng công nghệ vi sinh sản xuất chế phẩm bảo vệ thực vật
Mục tiêu của Bài 20: Ứng dụng công nghệ vi sinh sản xuất chế phẩm bảo vệ thực vật nhằm giúp các em biết được thế nào là chế phẩm sinh học bảo vệ thực vật; cơ sở khoa học và quy trình sản xuất chế phẩm vi khuẩn, virus và nấm trừ sâu. Dưới đây là nội dung của bài học, mời các em cùng theo dõi để tìm hiểu nội dung chi tiết.
-
Công nghệ 10 Bài 21: Ôn tập chương I
Nội dung của bài Ôn tập chương 1 dưới dây sẽ giúp các em nắm vững một số kiến thức cơ bản nhất về giống cây trồng, đất, phân bón và bảo vệ cây trồng nông, lâm nghiệp; biết được cơ sở khoa học và quy trình sản xuất chế phẩm vi khuẩn, virut và nấm trừ sâu;.... từ đó, chuẩn bị tốt cho kì thi kiểm tra học kì 1 sắp tới. Mời các em cùng theo dõi bài ôn tập.
- Trắc nghiệm Công nghệ 10 Bài 21: Ôn tập chương I
- Giải bài tập SGK Bài 21 Công nghệ 10
- Hỏi đáp về Ôn tập chương I - Công nghệ 10
10 trắc nghiệm 13 bài tập 20 hỏi đáp
Chủ đề Công Nghệ 10
- Chương 1: Giới thiệu chung về trồng trọt
- Chương 2: Đất trồng
- Chương 3: Phân bón
- Chương 4: Công nghệ giống cây trồng
- Chương 5: Phòng trừ sâu, bệnh hại cây trồng
- Chương 6: Kĩ thuật trồng trọt
- Chương 7: Trồng trọt công nghệ cao
- Chương 8: Bảo vệ môi trường trong trồng trọt
- Chương 1: Đại cương về công nghệ
- Chương 2: Vẽ kĩ thuật
- Chương 3: Thiết kế kĩ thuật
- Chủ đề 1. Giới thiệu chung về trồng trọt
- Chủ đề 2. Đất trồng
- Chủ đề 3. Phân bón
- Chủ đề 4. Công nghệ giống cây trồng
- Chủ đề 5. Phòng trừ sâu, bệnh hại cây trồng
- Chủ đề 6. Kĩ thuật trồng trọt
- Chủ đề 7. Trồng trọt công nghệ cao
- Chủ đề 8. Bảo vệ môi trường trong trồng trọt
- Chủ đề 1. Khái quát về công nghệ
- Chủ đề 2. Đổi mới công nghệ
- Chủ đề 3. Vẽ kĩ thuật cơ sở
- Chủ đề 4. Vẽ kĩ thuật ứng dụng
- Chủ đề 5. Thiết kế kĩ thuật
- Chương 2: Chăn Nuôi Thủy Sản Đại Cương
- Chương 3: Bảo Quản, Chế Biến, Nông, Lâm, Thủy Sản
- Chương 4: Doanh Nghiệp Và Lựa Chọn Lĩnh Vực Kinh Doanh
- Chương 5: Tổ Chức Và Quản Lý Doanh Nghiệp









